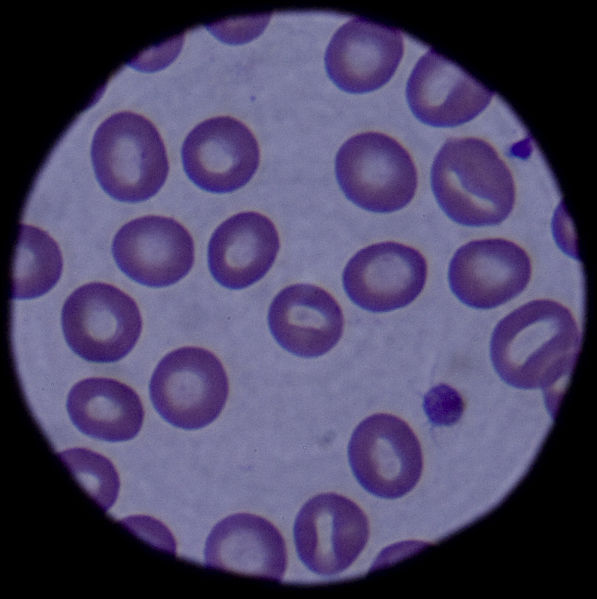
597px-Blood_cells_090304-F-5951M-108

Last month, two graduate students that I work with invited me to speak at a round-table event about blogging later in November. I agreed, enthusiastically, put it on the calendar, and then promptly stopped posting on my blog. The two things, I promise, don’t have anything to do with each other, but their juxtaposition nonetheless has made me more aware of both of them. If I’m going to go and talk about the benefits of blogging, what does it mean that I’ve gone inactive? And does there come a time when it’s better not to blog?
There is nothing worse than those blogs that never quite get off the ground, where the blogger posts promises about blogging and not much else. “I’ll be back soon.” Or, even worse, “I’m back! I’m committed,” and then nothing more. As one stumbles through the blogosphere, one sees many such entries. That’s one reason why I have not even signed on to explain my hiatus.
Yet, I do find that being on break from the blog has been yet another learning experience about blogging.
First, that I do sincerely miss it. I miss the sense of discipline, the accomplishment of writing something every week that’s self-contained and “done,” and the connectedness that comes with all the public and private responses I get. This has given me insight into the junkie nature of attention to one’s writing—I’ve never had much, but I can see easily how that gets to driving some writers, for better and for worse.
I have also learned that as much as I love the blog and feel devoted to it, there are other things that take priority. The main reason I haven’t been blogging is because I have been spending every spare minute I have working on the book with Oxford for which I have a contract. There are other secondary reasons—I’ve had to have a minor surgery, I’ve been out of town, I’ve been formulating a project and soliciting an illustrator for it, I’ve been back in the classroom again and attending to all the prosaic demands of the university bureaucracy—course descriptions, book orders for next term, making benefits decisions during open enrollment, etc. etc.
Frankly, I’ve also been trying not-so-successfully to deal with the stress and anxiety of it all. A couple of weeks ago, my neurologist’s nurse told me that my latest MRI looks “completely normal.” She asked if I’d been having any symptoms, and I reported to her that I seem basically fine but don’t feel like myself. I wondered if my forgetfulness, irritability, inability to get a training response to exercise, and lack of concentration are sequelae to my brain events or just middle age. After asking me a few questions, she came to a different conclusion.
You know how it is when someone tells you something that you already really know, but it just clicks? There’s an aha moment even though the idea is nothing new.
“I think,” the neurology nurse said, “that there’s nothing wrong with your brain. You have the classic symptoms of insomnia and anxiety. You need to get eight hours of sleep at least two or three nights a week.” (I was getting between three and six. Once a month, maybe seven.)
So, last week I discussed this with my endocrinologist. He’s one of the good ones—a doctor who cares, who knows his stuff, and who makes time to really listen. When I was in the hospital after my brain hemorrhage, either he or his nurse came by to see me every day, even though I was not under their care at the time.
Anyway, I came home with a new prescription to help me deal with the insomnia and anxiety, a very minor dosage of a mostly harmless medication. I feel better already. That’s not really the interesting part, though. The interesting part is that Dr. M. spoke to me very personally. I have never, ever had a physician do so before, and it was a red-letter day for me.
When I was telling him about how sometimes I would be in the car driving somewhere and forget how to get there, have to call my friend and ask which exit is the best for her house, he laughed and said, “That sounds just like me. I usually get off at the right exit, but sometimes I don’t remember how I got there.”
When I told him how I feel that the powers that be just make it harder and harder for me to do my job well, and how it seems that my colleagues who take short-cuts or behave selfishly are the ones that are rewarded, he nodded. I told him that I used to love my job and that I thought I always would, but that now I always have to force myself to find the good things in it and that if I won the lottery I would quit tomorrow. He said, “I feel the same way. The adminstrators are always telling us we are only allowed to spend five minutes with a patient, and I am always telling them that’s not enough for a Type 1 with a pump, but they don’t care.”
I told him that the medical appointments—all designed to maximize the amount the doctor can charge the insurance company—have run me ragged. I told him that I had to have a total of eight appointments to have the D&C I had a couple of weeks ago—the initial appointment where all we did was set up other appointments and then appointments for the first lab work, the ultrasound, the tests the doctor performed, the pre-op, the pre-op labwork at the hospital, the procedure itself, and then the post-op. “That’s eight appointments,” I said. “Not including all the procedures themselves and the waiting in offices, that’s eight hours of me just driving around town, a whole day of work just driving around so that the docs can charge more. The number of appointments could certainly have been cut in half. Easily.
He looked chagrined, and we agreed that the tail is wagging the dog. We agreed that these circumstances are designed to promote those who don’t care about the quality of their work, and that it’s a mystery why we all seem to agree to live this way.
“I’m not mentally ill,” I said to him, and he agreed. “I need medication because we have come to find ourselves living in a world that’s intolerable.”
In fact, the percentage of my friends and relatives and their kids and their spouses and their parents that take some kind of psychotropic medication is enormous. At least one in five Americans is now taking at least one such medication, according to the American Psychological Association. And the percentage of people who aren’t taking prescription help often participate widely in the phenomenon known as self-medicating via alcohol, caffeine, nicotine, and illegal recreational drugs. (Studies noted by Mental Health America and Health Services Research indicate the severity of this issue.)
The APA notes that the recent rapid increase in the use of these medications indicates “inappropriate prescribing,” and I agree. I have known people whose diagnoses I thought were overblown and who seem to me worse off than before they were medicated. The insurance companies and the medical world have tended to turn away from the hard work of intensive psychotherapy for those with real issues and have turned toward the easy pop-a-pill (or four) mentality.
But there is also a societal change going on that contributes to this in a different way, I believe. I believe that recent years’ move away from concepts of the public good toward more personal greed and supposed “self-reliance” have turned us more and more toward dog-eat-dog. Community is not emphasized, helping out is not emphasized—it’s every man, woman, child, and dog for itself. This leads inevitably to stress.
My father retired when he was 56 years old. He has lived the past twenty years in a secure retirement. He did some consulting work, he helps his wife with her small collectibles business, he got into crime writing workshops and wrote a novel, he plays tennis, he’s taken care of aging and infirm colleagues and relatives. And now he and his wife babysit her grandchildren. He has remained an active and contributing member of society, and he is a classic case of why the middle-class is a great thing.
We are unfortunately losing the middle class. My brother and I—highly educated, hard-working people who had our first jobs by age 16 or 17—have no secure retirement to look forward to. We only hope it will be there, and there’s no way that either of us will be able to retire before we’re nearly 70 years old. The future is even less sanguine for my brother’s daughter and for my students.
These are choices our society has been making and continues to make. There is plenty of money in our society, though it is consolidated in fewer and fewer hands. And there are plenty of us who want to help each other and be parts of a community, not just self-protective egotists. Even those that I encounter in my work life who seem the most selfish, self-promoting, and communally harmful seem to me to really wish for something else. They only feel that they are doing what they have to do to survive. Who can condemn them for that? I myself have turned away from demands I can’t handle, that I have felt might sink me.
Sometimes I marvel over the fact that there’s so much stress involved in being an English professor. I always think, “Hell, it’s not like I’m an ER doctor or an airplane pilot who could take out hundreds of lives with one error.” Not to mention that I don’t live in a war-torn place or one where I’m likely to starve. As the Rolling Stones song points out, though, even cooking dinner can be a trial, and there’s something stressful about the compromises that we make to have our comfortable lives. Vivian Gornick captured the same idle desperation of English departments in her wonderful essay “At the University: Little Murders of the Soul.” There is nothing more deadening than corporate expectations (or perhaps housewifely ones). And corporate expectations have taken over everywhere. My students can’t even have a minimum-wage job nowadays without being constantly harangued about their enthusiasm.
I have a hard time reconciling this high level of psychological distress across society with the idea that we are all living the way we choose to live. If we have all this choice in our lives that the gurus speak of, if we create the world we dream of, if we only have to envision success faithfully in order to get it, could we please envision something more benign, something more cooperative and less manipulative?
I know this is probably not stuff I should discuss in public on a blog with my name on it. That’s probably one more reason why I’ve been hanging back from blogging lately–just too many unspeakables on my mind. But I just have to say that if this is scandalous, then I have to laugh. More likely, of course, it could give an enemy a vulnerability to attack. But one thing I have always liked about myself—among the admittedly many things I’ve longed to change—is that I go ahead and do what I think is right. I go ahead and say what I’m thinking. I try to do this in ways that aren’t designed to hurt others, but I am not afraid to be hurt myself. I’d rather be real than afraid. I’m not invulnerable, but I am brave. I don’t mean to make more of that than it is. There are many things I am not that I would prefer to be. This is no Facebook brag or depiction of my life as peachy and perfect, of me as a hero of all that I survey, a wild success, a best human in the world. Nope, nope, nope. But I do marshal on. Today, a little more calmly.